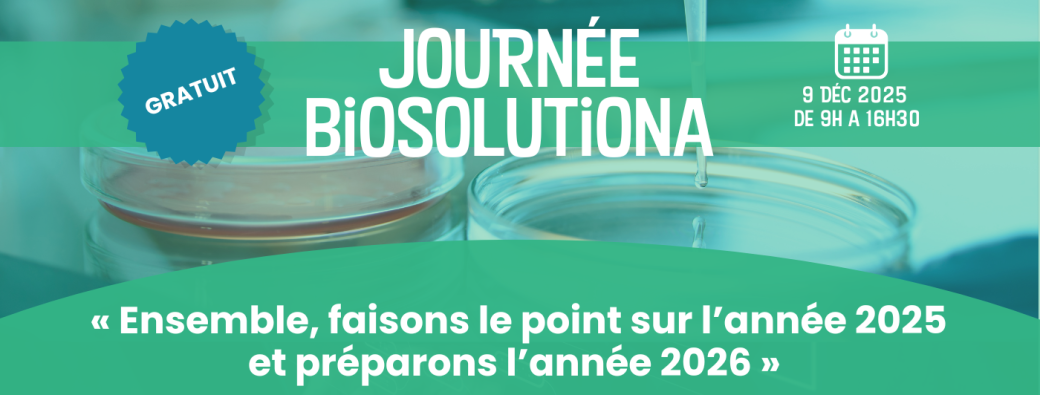
Journée BiosolutioNA  : Ensemble clôturons l’année 2025 !

Journée BiosolutioNA : Ensemble clôturons l’année 2025 !
Tue Dec 09, 2025 from 09:00 AM to 04:30 PM
Timezone : Europe/Paris
Bordeaux, France
Journée BiosolutioNA : Ensemble clôturons l’année 2025 ! En partenariat avec Xylofutur et Innovin, Agri Sud-Ouest Innovation vous donne rendez-vous le mardi 9 décembre 2025 de 9h à 16h30.
Objectif : « Ensemble, faisons le point sur l’année 2025 et préparons l’année 2026 ».
Événement réservé aux membres du cluster BiosolutioNA.
